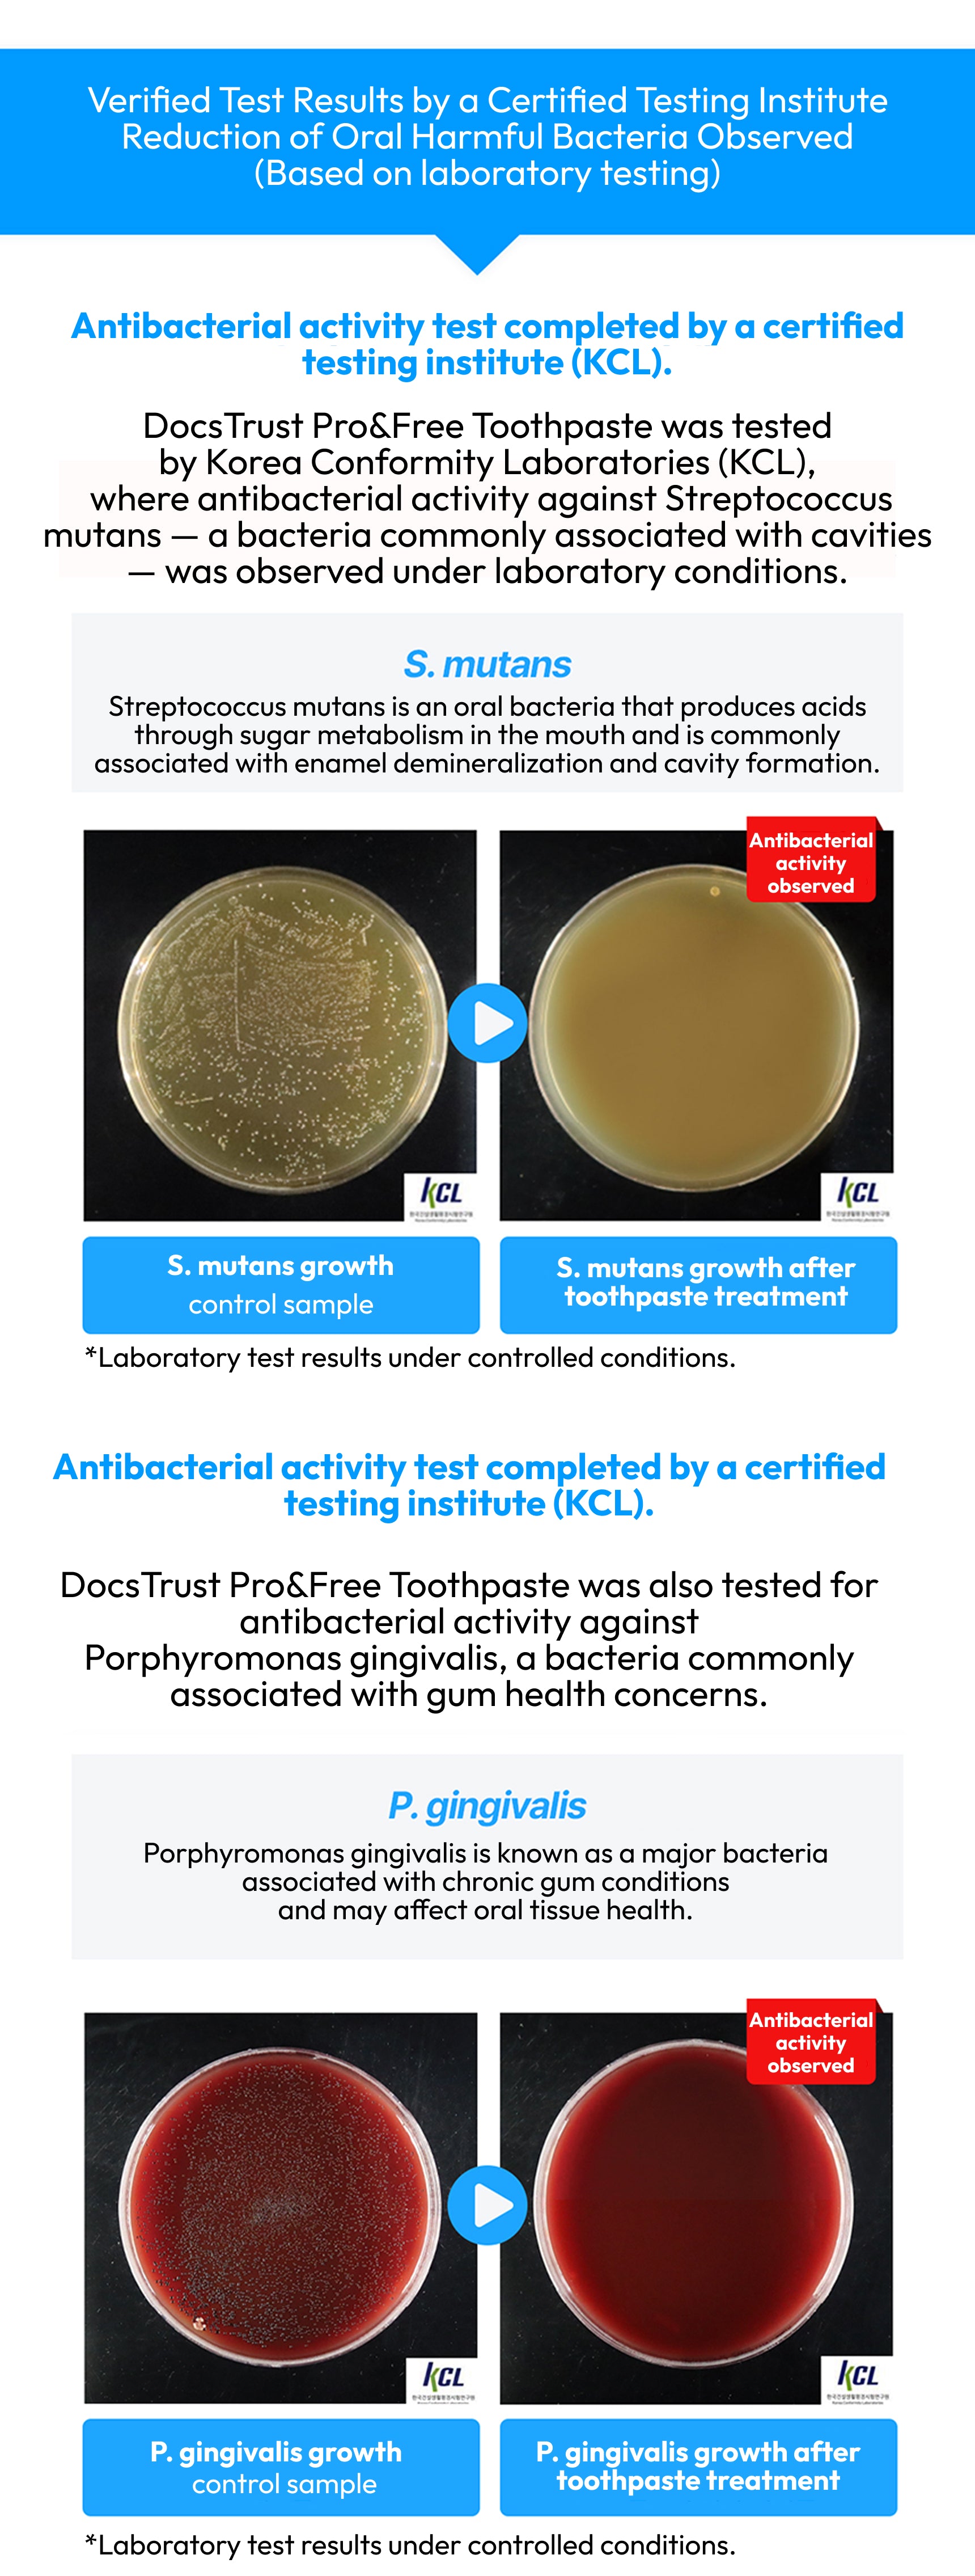

- Active Ingredients
⦁ Silicon Dioxide
⦁ Tocopheryl Acetate (Vitamin E)
- Other Ingredients
Purified Water, D-Sorbitol Solution, Hydrolyzed Collagen, Concentrated Glycerin, Xylitol, Enzyme-Treated Stevia, Hydroxyapatite, Ascorbic Acid, Sodium Bicarbonate, Dental-Type Silica, Carboxymethylcellulose Sodium, Xanthan Gum, Sodium Gluconate, L-Menthol, Peppermint Oil, Fermented Lactic Acid Bacteria Filtrate, Glycyrrhiza (Licorice) Extract, Rosemary Leaf Extract, Sage Leaf Extract, Complex Herbal Extract, Chamomile Extract, Centella Asiatica Extract, Aloe Vera Leaf Extract, Turmeric Extract, Propolis Extract
✔ Fluoride-Free
✔ Contains Probiotics & Propolis
✔ Plant-Derived Botanical Extracts